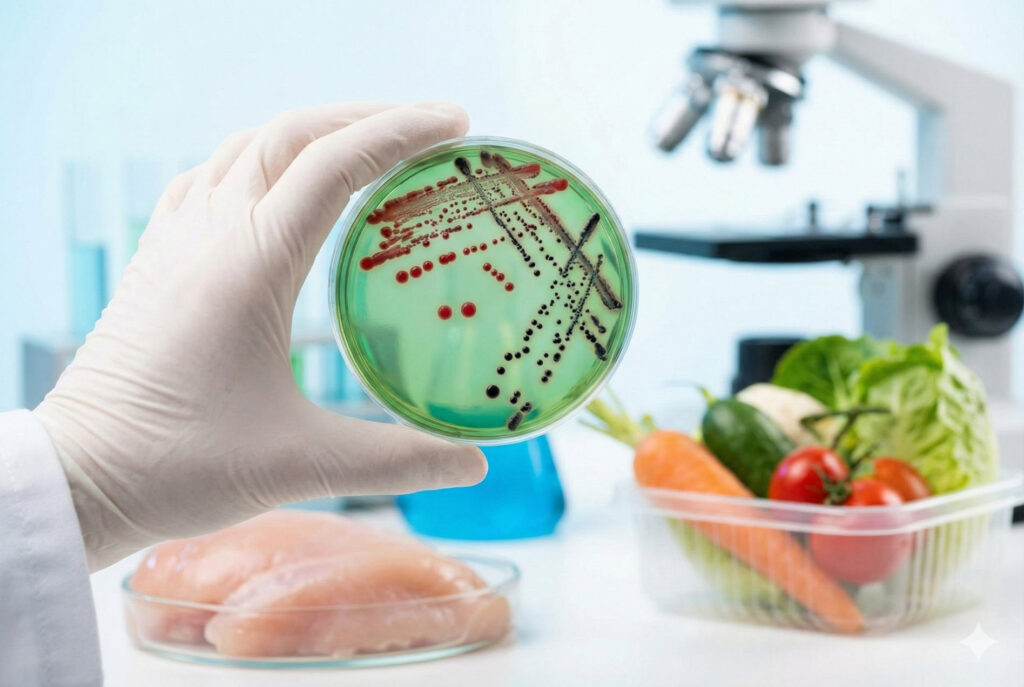
A gloved hand showing Salmonella colonies growing on XLD agar plates during culture confirmation against a background of various food items.

Salmonella is one of the most common bacterial pathogens responsible for foodborne illnesses worldwide. It can contaminate various food products, including poultry, eggs, meat, fruits, and vegetables, leading to severe gastrointestinal diseases. Ensuring that food products are free from Salmonella is critical for public health and food safety. This article explores the importance of Salmonella testing and analysis in food, highlighting key testing methods, biochemical test methods, and the use of Salmonella test kits.
Why Is Salmonella Testing Important?
Salmonella contamination poses a significant health risk, with millions of cases of salmonellosis reported each year globally. The bacteria can lead to symptoms such as diarrhea, abdominal cramps, fever, and, in severe cases, death. As a result, food producers and manufacturers are required to regularly test for Salmonella to prevent outbreaks and ensure regulatory compliance.
Key Reasons for Salmonella Testing:
- Public Health Protection: Identifying and eliminating Salmonella in food prevents foodborne illnesses and protects consumers.
- Regulatory Compliance: Food manufacturers must comply with local, national, and international regulations that mandate Salmonella testing, including standards set by the FDA, USDA, and European Food Safety Authority (EFSA).
- Brand Reputation: Regular Salmonella testing helps food businesses avoid product recalls, legal liabilities, and damage to their reputation due to contamination incidents.
Critical Role of Sampling Plans
Testing for Salmonella is only as effective as the sampling plan used. Because Salmonella contamination is often nonuniformly distributed (clustering in “hot spots”), testing a single random sample may yield a false negative.
To ensure statistical validity, food safety professionals often rely on sampling plans defined by the International Commission on Microbiological Specifications for Foods (ICMSF). A robust plan typically involves:
- Sample Size: Moving beyond standard 25g samples to larger composites (e.g., 375g) for high-risk foods to increase the probability of detection.
- Representative Sampling: Collecting multiple subsamples (n=60 or n=30) from a lot to form a composite, ensuring the test represents the entire production batch.
- Aseptic Technique: Ensuring samples are collected with sterile tools to prevent cross-contamination during the process.
Testing Methods for Salmonella in Food
There are several testing methods available for detecting Salmonella in food, each with its own advantages and limitations. These methods are designed to identify the presence of Salmonella in raw and processed food products, ensuring that they are safe for consumption.
1. Culture-Based Methods
Culture-based methods are considered the gold standard for Salmonella detection. These methods involve the enrichment of samples in selective broths to increase the number of Salmonella cells, followed by plating on selective agar media to isolate the bacteria.
- Step 1: Pre-Enrichment: Food samples are incubated in a non-selective broth (e.g., Buffered Peptone Water) to recover injured or stressed Salmonella cells.
- Step 2: Selective Enrichment: The pre-enriched sample is transferred to selective broths (e.g., Rappaport-Vassiliadis or Tetrathionate Broth) to promote the growth of Salmonella while inhibiting other bacteria.
- Step 3: Isolation on Agar: The enriched sample is plated onto selective agars (e.g., XLD agar, Hektoen Enteric agar) that differentiate Salmonella based on colony morphology.
- Step 4: Confirmation: Suspected Salmonella colonies are confirmed using biochemical tests, serotyping, or PCR.
Advantages: Reliable, accurate, and able to detect low levels of contamination.
Limitations: Time-consuming, requiring up to 5-7 days for results.
2. PCR-Based Methods
Polymerase Chain Reaction (PCR) is a molecular method used to detect the genetic material of Salmonella. PCR assays target specific DNA sequences unique to Salmonella, making it a highly sensitive and specific method for pathogen detection.
- Step 1: Sample Preparation: Food samples undergo a pre-enrichment step to increase the concentration of Salmonella cells.
- Step 2: DNA Extraction: DNA is extracted from the enriched sample.
- Step 3: PCR Amplification: The extracted DNA is amplified using specific primers for Salmonella genes (e.g., invA gene).
- Step 4: Detection: The presence of amplified DNA is detected using gel electrophoresis, fluorescence, or other methods.
Advantages: Rapid, highly sensitive, and can provide results in as little as 24-48 hours.
Limitations: Requires specialized equipment and technical expertise.
3. Immunoassay Methods
Immunoassays, such as enzyme-linked immunosorbent assays (ELISA), are used to detect Salmonella antigens in food samples. These methods rely on the specific interaction between antibodies and Salmonella antigens to detect the presence of the bacteria.
- Step 1: Sample Preparation: Food samples are enriched in selective media to increase Salmonella levels.
- Step 2: Antigen-Antibody Reaction: The enriched sample is tested using antibodies that specifically bind to Salmonella antigens.
- Step 3: Detection: A color change or signal is generated when antibodies bind to Salmonella antigens, indicating a positive result.
Advantages: Simple, cost-effective, and does not require complex equipment.
Limitations: Lower sensitivity compared to molecular methods like PCR.
Salmonella Biochemical Test Methods
Biochemical tests are commonly used to confirm the presence of Salmonella following initial isolation. These tests identify Salmonella based on its biochemical properties, such as sugar fermentation and enzyme activity.
1. Triple Sugar Iron (TSI) Agar Test
The TSI agar test differentiates bacteria based on their ability to ferment sugars and produce hydrogen sulfide (H2S).
- Interpretation: Salmonella typically produces an alkaline slant and acidic butt on TSI agar, along with H2S production, indicated by black precipitate in the medium.
2. Urease Test
The urease test determines the ability of bacteria to hydrolyze urea to ammonia using the enzyme urease. Salmonella is urease-negative, meaning it does not produce urease.
- Interpretation: A negative result (no color change) indicates the presence of Salmonella.
3. Lysine Iron Agar (LIA) Test
The LIA test differentiates Salmonella based on its ability to decarboxylate lysine and produce H2S.
- Interpretation: Salmonella typically produces a purple slant and butt with H2S production (blackening in the medium).
4. Serotyping
Serotyping is a biochemical and immunological method used to identify specific Salmonella serotypes based on the O (somatic) and H (flagellar) antigens.
- Interpretation: Serotyping helps differentiate between different strains of Salmonella, such as Salmonella enterica serovars typhimurium or enteritidis.
Comparison of Salmonella Testing Methods
Choosing the right method depends on your turnaround time requirements, budget, and sample volume.
| Feature | Culture-Based (Gold Standard) | PCR (Molecular) | ELISA/LFA (Immunoassay) |
| Time to Result | 5–7 Days | 24–48 Hours | 24–48 Hours |
| Sensitivity | High | Very High | Moderate to High |
| Cost | Low | High | Moderate |
| Labor Requirement | High | Specialized | Low to Moderate |
| Best For | Confirmation & Regulatory Compliance | Rapid Screening & Perishables | High-Volume Screening |
Salmonella Testing using Commercially Available Kits
Commercially available Salmonella test kits are widely used in food testing laboratories due to their ease of use and rapid results. These kits are designed for detecting Salmonella in various food products, including meats, poultry, dairy, and processed foods.
1. Lateral Flow Immunoassay (LFIA) Kits
Lateral flow immunoassay (LFIA) kits are rapid, easy-to-use devices that detect Salmonella antigens in food samples. The sample is applied to a test strip, and results are visible as colored lines within minutes.
Advantages: Quick, simple, and suitable for on-site testing.
Limitations: Lower sensitivity compared to lab-based methods.
2. PCR-Based Test Kits
PCR-based Salmonella test kits provide a fast and accurate method for detecting Salmonella DNA. These kits include all the necessary reagents and protocols for PCR amplification and detection.
Advantages: Highly sensitive and specific with rapid results.
Limitations: Requires specialized equipment and trained personnel.
3. ELISA Test Kits
ELISA-based Salmonella test kits detect the presence of Salmonella antigens using antibodies and a colorimetric detection system. These kits are commonly used in laboratory settings for high-throughput testing.
Advantages: Cost-effective and suitable for large-scale testing.
Limitations: Lower sensitivity compared to PCR-based methods.
Overcoming Matrix Interference
Not all food products react the same way in a laboratory setting. Certain complex matrices can inhibit the chemical reactions required to detect Salmonella, leading to false negatives.
- High-Fat Foods: Products like peanut butter, chocolate, and nut pastes can protect bacteria from heat and enrichment media.
- Spices & Herbs: Cinnamon, oregano, and cloves have natural antimicrobial properties that can kill Salmonella in the test tube before it is detected.
- Probiotics: High levels of beneficial bacteria in yogurt or supplements can outgrow Salmonella, masking its presence.
When requesting testing, it is vital to inform the laboratory of the specific food matrix so they can use validated neutralization methods or specific enrichment broths (e.g., adding milk for chocolate samples).
What Happens After a Positive Result?
If a rapid test (PCR or ELISA) returns a “Presumptive Positive,” the product cannot be released. The lab must immediately perform a cultural confirmation, using the agar plate methods described above, to verify the result. If confirmed, the facility must initiate a root cause analysis (RCA) to identify the source of contamination.
Regulatory Standards & Reference Methods
For test results to be recognized by auditors and regulatory bodies, laboratories must strictly follow validated reference methods. Common standards include:
- ISO 6579-1:2017: The international horizontal method for the detection of Salmonella.
- FDA BAM Chapter 5: The standard method for foods regulated by the US FDA (produce, seafood, dairy).
- USDA MLG 4.13: The method required for meat, poultry, and egg products regulated by the USDA.
- AOAC Official Methods: Validation protocols often used for proprietary rapid test kits to ensure they perform equivalent to the reference methods.
How Contract Laboratory Assists with Microbiology Testing
Salmonella testing and analysis are crucial components of food safety management. With various testing methods available, from traditional culture-based techniques to rapid molecular and immunoassay methods, food producers and laboratories can detect and prevent Salmonella contamination in food products. By employing reliable testing methods, manufacturers can ensure compliance with regulatory standards, protect public health, and maintain consumer trust in their products.
If you are a food manufacturer, producer, or distributor in need of Salmonella testing, submit a lab request to get free quotes from accredited labs.
Frequently Asked Questions (FAQs)
Rapid screening methods (PCR/ELISA) typically provide negative results in 24–48 hours. However, if a sample is presumptive positive, confirmation via culture methods can take an additional 3–5 days.
A presumptive result means a rapid test detected potential Salmonella DNA or antigens. It is not final. A confirmed result means the bacteria have been isolated and identified on a growth medium.
This article was created with the assistance of Generative AI and has undergone editorial review before publishing.